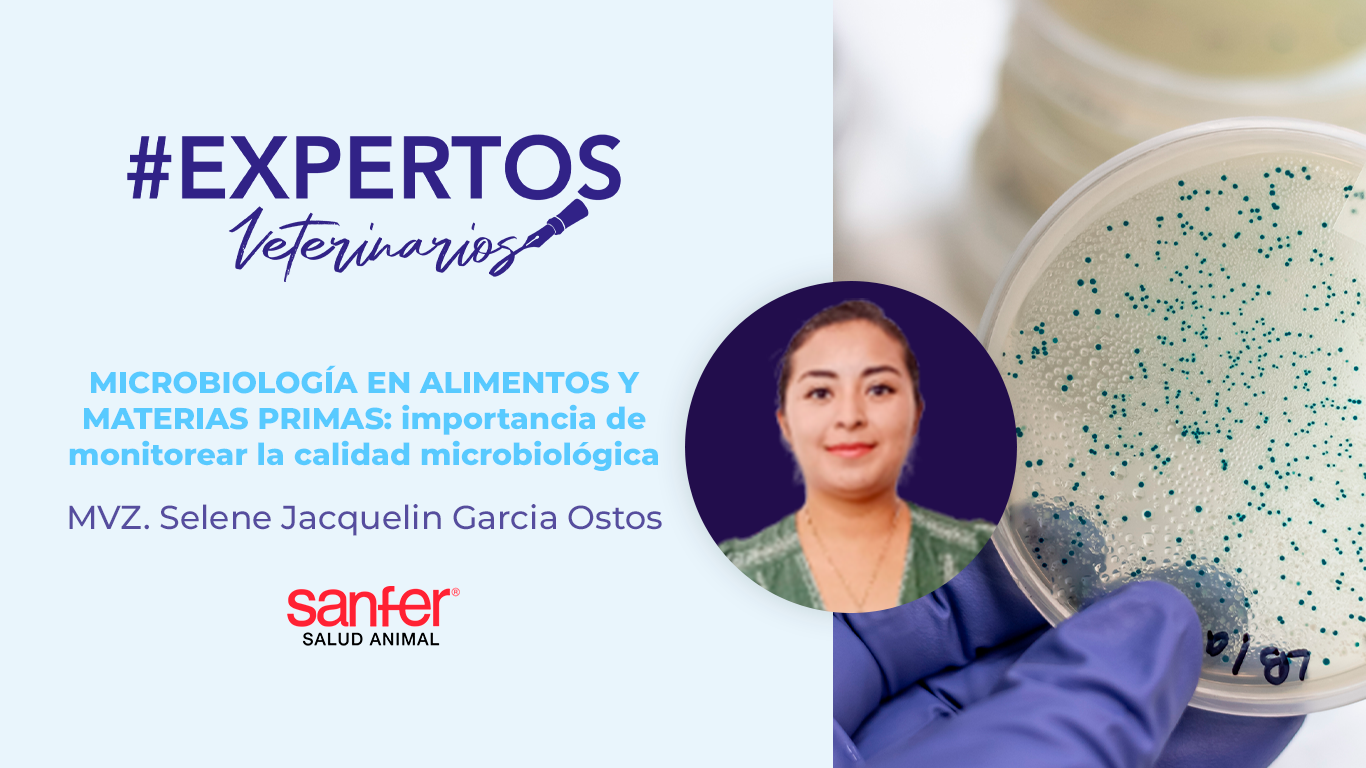
MICROBIOLOGÍA EN ALIMENTOS Y MATERIAS PRIMAS: importancia de monitorear la calidad microbiológica

agosto 11, 2025
Los parásitos son microorganismos que viven a expensas de otro ser causándole perjuicio; en los caninos, los helmintos afectan principalmente el tracto gastrointestinal y constituyen un riesgo para la salud humana; siendo fuente de contaminación de...